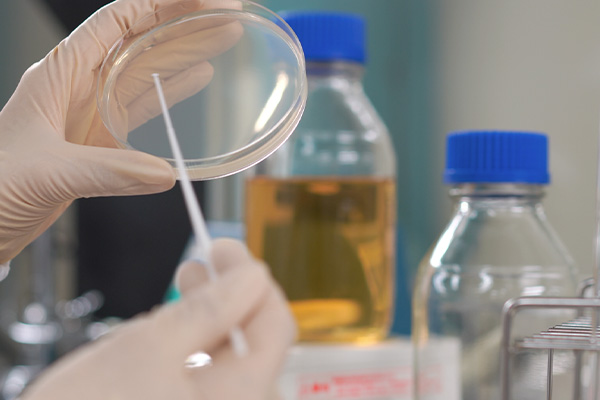
おいしさの安心安全を保証する

お客さまに安心してUmiosの商品を選んでいただくため、各種計測データを用いたおいしさの要因究明、微生物制御による商品の安全性担保、正しい情報発信によるお客さまの健康サポートなど、科学的な知見を取得・活用することでUmiosの“おいしさ”を支える研究を行っています。
おいしさの要因を究明する
食品のおいしさについて、におい・食感・味などの分析を行い、開発に活用できるデータの収集を行っています。ヒトの感覚と最新技術を融合させながら、おいしさとは何かについて日々研究しています。

おいしさの安全安心を保証する
商品の賞味期限の設定など、安全で安心な商品の提供に貢献しています。また、大学や研究機関との共同研究によって食品中の微生物を制御するための技術を探求しています。
Bacillus cereus 迅速同定
食中毒の原因菌種であるBacillus cereusは従来の方法(16Sr RNAシーケンス)では同定することが難しいことが知られています。そこで、当研究所ではNITE(※)との共同研究によってMALDI-TOF MSによる Bacillus cereusの迅速同定法を開発しました。 ※ NITE: 独立行政法人製品評価技術基盤機構

健康をサポートする
特定保健用食品や機能性表示食品のような、食品の機能性に関するわかりやすい表示制度を活用し、水産物由来の健康栄養素に関する正しい知見でお客さまの健康をサポートします。

特定保健用食品「DHAリサーラソーセージ」
DHAとEPAにより血液中の中性脂肪を下げる効果が期待できる特定保健用食品「DHA リサーラ ソーセージ」の製品を紹介します。


